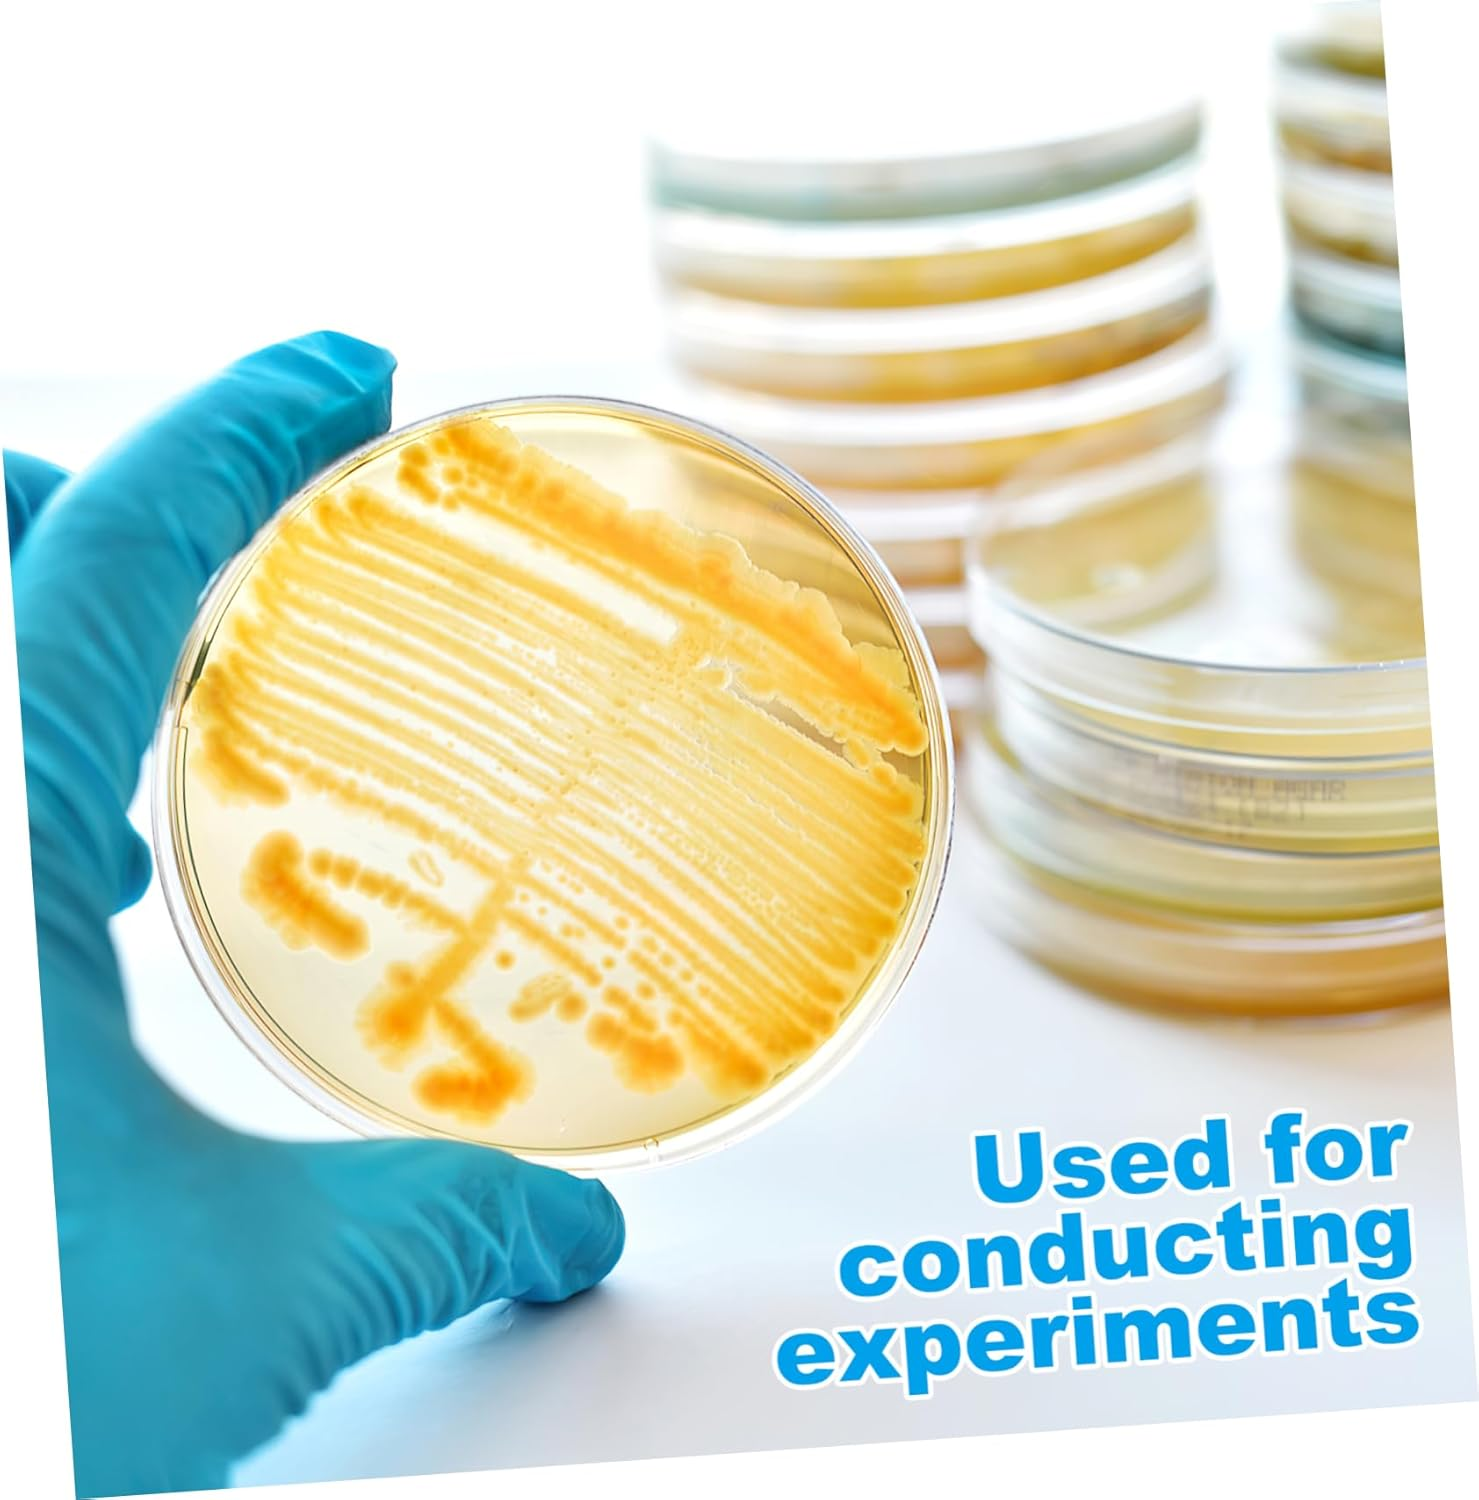
Didiseaon 10Pcs Pre-Poured Agar Plates Nutrient Agar Petri Dishes for Science Experiments Thick Agar for Growth Laboratory Supplies for Use Prepoured Petri Dishes image number 2

Didiseaon 10Pcs Pre-Poured Agar Plates Nutrient Agar Petri Dishes for Science Experiments Thick Agar for Growth Laboratory Supplies for Use Prepoured Petri Dishes


Didiseaon 10Pcs Pre-Poured Agar Plates Nutrient Agar Petri Dishes for Science Experiments Thick Agar for Growth Laboratory Supplies for Use Prepoured Petri Dishes
- Laboratory:fresh plates promote faster growth as compared to aged stored plates,agar dish
- Agar plates pre poured:great for stem science, technology, engineering, mathematics for young students,agar experiment
- Lab petri plate dish:professional and safe, these plates are pre-poured, don't waste time pouring agar,agar plates for mycology
- Pre poured agar dishes:this pre-poured agar science kit will engage your students, friends and siblings for a long time,pre poured agar plate
- Pre made nutrient agar petri dishes:used for a wide range of applications, including culture storage, isolation of pure cultures, or simply general culture,prepored agar plates
Package List
10 x Agar Plates
Characteristics
-Size:7.00X7.00X1.00cm/2.75X2.75X0.39in agar and petri dish
-Material:Agar petri dish agar
-Color:Transparent petri dishes
-Professional and safe, these plates are pre-poured. Don't waste time pouring agar agar petri dishes individual.
-It is made of strong material, which is a useful tool for you in science experiments pre poured agar petri dish.
-They have a thick layer of agar which promotes growth, easy to use agar plates pre poured.
-These plates are the great size for school-aged for use in science class agar plate petri dishes.
-Great for STEM science, technology, engineering, mathematics for young students pre made nutrient agar petri dishes.
Goods Description
pre filled petri dishes It is made of strong materials and craftsmanship, and practical, and can provide you with stable working performance.prepored agar plates If you are looking for professional and reasonably agar plates, then your research is here.pre poured agar petri dishes That's because our products can meet your needs
- Brand: Didiseaon
- Material: Agar
- Product dimensions: 7 x 7 x 1 cm; 200 Grams
- Item Weight: 200 g
- Model Number: 098270550UA2S
- Colour: Transparent
-
In Stock